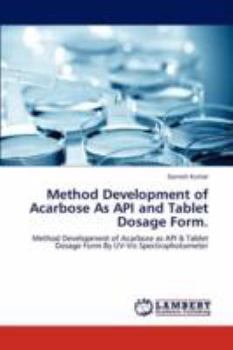
Paperback Method Development of Acarbose As API and Tablet Dosage Form. Book

Method Development of Acarbose As API and Tablet Dosage Form.
A simple rapid spectrophotometeric method has been developed for estimation of acarbose from bulk drug and tablet dosage form by using potassium permagnate and sodium hydroxide as oxidizing agent. The... This description may be from another edition of this product.
Format:Paperback
Language:English
ISBN:3846599654
ISBN13:9783846599655
Release Date:December 2011
Publisher:LAP Lambert Academic Publishing
Length:56 Pages
Weight:0.21 lbs.
Dimensions:0.1" x 6.0" x 9.0"
Customer Reviews
0 rating